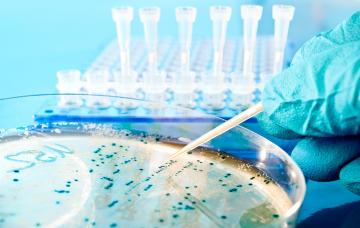
Diagnóstico de la leishmaniasis Diagnóstico de la leishmaniasis

Leishmaniasis

Por: Dr. Nelson Caballero
Colaborador de la Asociación Fontilles y coordinador médico de la Asociación para el Desarrollo de los pueblos (ADP)
- 1

Qué es la leishmaniasis
La leishmaniasis es una enfermedad infecciosa causada por parásitos, que puede afectar a la piel y las mucosas, o a la médula ósea, el hígado y el bazo.
Leer más - 2

Cadena de transmisión de la leishmaniasis
En la cadena de transmisión de la leishmaniasis intervienen el agente infeccioso, el vector, el reservorio, y el huésped humano susceptible.
Leer más - 3

Síntomas y tipos de leishmaniasis
Los síntomas de la leishmaniasis varían según la cepa de la Leishmania, el medioambiente, y la respuesta inmune del huésped. Conoce las 5 formas clínicas.
Leer más - 4

Diagnóstico de la leishmaniasis
El diagnóstico de leishmaniasis se basa en los antecedentes epidemiológicos, los síntomas y examen de las lesiones, y estas pruebas de laboratorio.
Leer más - 5

Tratamiento de la leishmaniasis y prevención
El tratamiento de leishmaniasis es con antimoniales pentavalentes, y en caso de resistencia del parásito a estos se usan otros fármacos que describimos.
Leer más